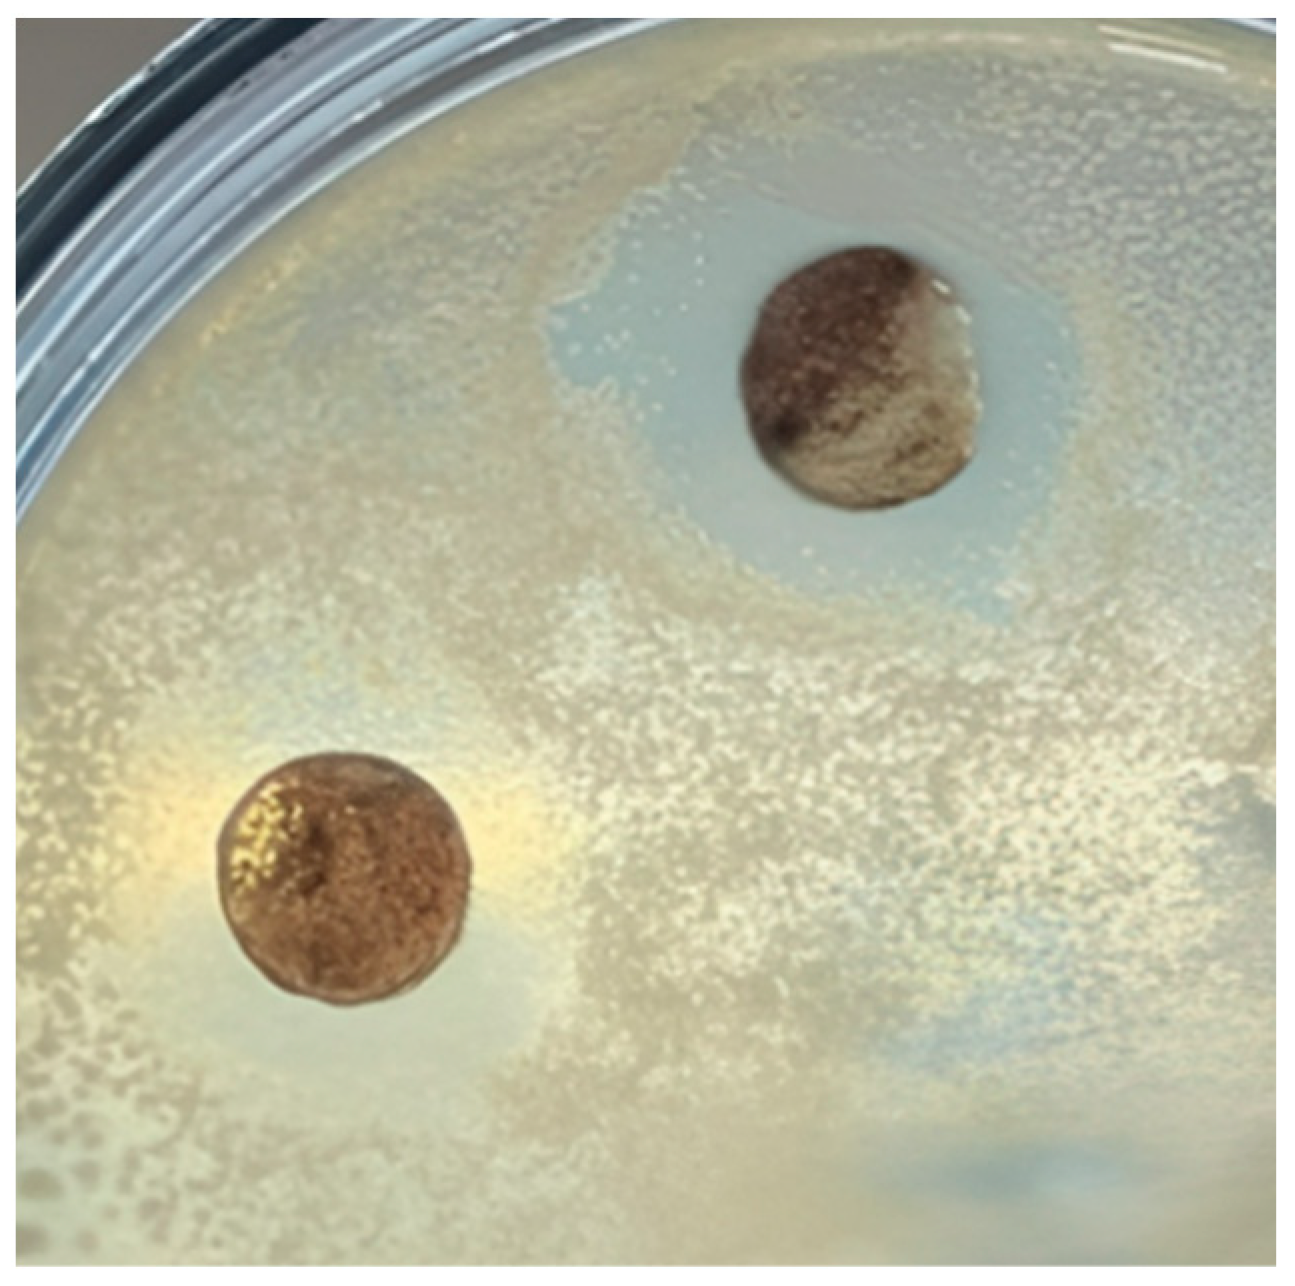
Processes 12 01116 g002

Bacteriostatic Activity of Janthinobacterium lividum and Purified Violacein Fraction against Clavibacter michiganensis
Abstract
1. Introduction
2. Materials and Methods
2.1. Bacterial Strains and Materials
2.2. Evaluation of Sensitivity of Clavibacter michiganensis VKM Ac-1402 to Janthinobacterium lividum VKM B-3705D
2.3. Evaluation the Nature of the Interaction between Clavibacter michiganensis VKM Ac-1402 and Janthinobacterium lividum VKM B-3705D
2.4. Cultivation of Janthinobacterium lividum VKM B-3705D and Preparation of Violacein Fraction in DMSO
2.5. Evaluation of Sensitivity of Clavibacter michiganensis VKM Ac-1402 to Violacene Fraction in DMSO
2.6. Evaluation of the Effect of Violacein Fraction in DMSO on the Growth Properties of Clavibacter michiganensis VKM Ac-1402
2.7. Evaluation of the Effect of the Violacein Fraction in DMSO on the Activity of Crude Adenosine Triphosphatase (EC 3.6.1.3) of the Bacterium Clavibacter michiganensis VKM Ac-1402
2.8. Atomic Force Microscopy (AFM) Study of the Influence of Violacein Extract on Morphometric Properties of Clavibacter michiganensis VKM Ac-1402 Cells
2.9. Statistical Analysis Methods
3. Results and Discussion
3.1. Evaluation of Sensitivity of Clavibacter michiganensis VKM Ac-1402 to Janthinobacterium lividum VKM B-3705D
3.2. Evaluation the Nature of the Interaction between Clavibacter michiganensis VKM Ac-1402 and Janthinobacterium lividum VKM B-3705D
3.3. Cultivation of Janthinobacterium lividum VKM B-3705D and Preparation of Violacein Fraction in DMSO
3.4. Evaluation of the Sensitivity of Clavibacter michiganensis VKM Ac-1402 to the Violacein Fraction in DMSO
3.5. Evaluation of the Effect of Violacein Fraction in DMSO on the Growth Properties of Clavibacter michiganensis VKM Ac-1402
3.6. Changes in the Morphometric Properties of Bacterial Cells in the Presence of the Violacein Fraction and Solvent
3.7. Effect of the Violacein Fraction in DMSO on the Activity of Crude Adenosine Triphosphatase (EC 3.6.1.3) of the Bacterium Clavibacter michiganensis VKM Ac-1402
4. Conclusions
Supplementary Materials
Author Contributions
Funding
Data Availability Statement
Conflicts of Interest
References
- Ignatov, A.N.; Punina, N.V.; Matveeva, E.V.; Kornev, K.P.; Pekhtereva, E.S.; Polityko, V.A. New pathogens of bacteriosis and forecast of their spread in Russia. Plant Prot. Quar. 2009, 4, 38–40. [Google Scholar]
- Kleitman, F.; Barash, I.; Burger, A.; Iraki, N.; Falah, Y.; Sessa, G.; Weinthal, D.; Chalupowicz, L.; Gartemann, K.H.; Eichenlaub, R.; et al. Characterization of a Clavibacter michiganensis subsp. michiganensis population in Israel. Eur. J. Plant Pathol. 2008, 121, 463–475. [Google Scholar] [CrossRef]
- Nandi, M.; Macdonald, J.; Liu, P.; Weselowski, B.; Yuan, Z.-C. Clavibacter michiganensis sp. michiganensis: Bacterial canker of tomato, molecular interactions and disease management. Mol. Plant Pathol. 2018, 19, 2036–2050. [Google Scholar] [CrossRef] [PubMed]
- Wang, Y.; Deng, S.; Li, Z.; Yang, W. Advances in the Characterization of the Mechanism Underlying Bacterial Canker Development and Tomato Plant Resistance. Horticulturae 2022, 8, 209. [Google Scholar] [CrossRef]
- Flügel, M.; Becker, A.; Gartemann, K.H.; Eichenlaub, R. Analysis of the interaction of Clavibacter michiganensis subsp. michiganensis with its host plant tomato by genome-wide expression profiling. J. Biotechnol. 2012, 160, 42–54. [Google Scholar] [CrossRef] [PubMed]
- Nakayasu, M.; Ohno, K.; Takamatsu, K.; Aoki, Y.; Yamazaki, S.; Takase, H.; Shoji, T.; Yazaki, K.; Sugiyama, A. Tomato roots secrete tomatine to modulate the bacterial assemblage of the rhizosphere. Plant Physiol. 2021, 186, 270–284. [Google Scholar] [CrossRef] [PubMed]
- Balaji, V.; Mayrose, M.; Sherf, O.; Jacob-Hirsch, J.; Eichenlaub, R.; Iraki, N.; Manulis-Sasson, S.; Rechavi, G.; Barash, I.; Sessa, G. Tomato Transcriptional Changes in Response to Clavibacter michiganensis subsp. michiganensis Reveal a Role for Ethylene in Disease Development. Plant Physiol. 2008, 146, 1797–1809. [Google Scholar] [CrossRef]
- Yokotani, N.; Hasegawa, Y.; Sato, M.; Hirakawa, H.; Kouzai, Y.; Nishizawa, Y.; Yamamoto, E.; Naito, Y.; Isobe, S. Transcriptome analysis of Clavibacter michiganensis subsp. michiganensis-infected tomatoes: A role of salicylic acid in the host response. BMC Plant Biol. 2021, 21, 476. [Google Scholar] [CrossRef] [PubMed]
- Gust, A.A. Peptidoglycan Perception in Plants. PLoS Pathog. 2015, 11, e1005275. [Google Scholar] [CrossRef]
- Lee, S.M.; Kong, H.G.; Song, G.C.; Ryu, C.M. Disruption of Firmicutes and Actinobacteria abundance in tomato rhizosphere causes the incidence of bacterial wilt disease. ISME J. 2021, 15, 330–347. [Google Scholar] [CrossRef]
- Information in the “State Catalog of Pesticides and Agrochemicals Allowed for Use in the Russian Federation”. Available online: https://mcx.gov.ru/ministry/departments/departament-rastenievodstva-mekhanizatsii-khimizatsii-i-zashchity-rasteniy/industry-information/info-arkhiv/ (accessed on 22 August 2023).
- Dobrzyński, J.; Jakubowska, Z.; Kulkova, I.; Kowalczyk, P.; Kramkowski, K. Biocontrol of fungal phytopathogens by Bacillus pumilus. Front. Microbiol. 2023, 14, 1194606. [Google Scholar] [CrossRef] [PubMed]
- Lyakhovchenko, N.S.; Abashina, T.N.; Polivtseva, V.N.; Senchenkov, V.Y.; Pribylov, D.A.; Chepurina, A.A.; Nikishin, I.A.; Avakova, A.A.; Goyanov, M.A.; Gubina, E.D.; et al. A Blue-Purple Pigment-Producing Bacterium Isolated from the Vezelka River in the City of Belgorod. Microorganisms 2021, 9, 102. [Google Scholar] [CrossRef] [PubMed]
- Lyakhovchenko, N.S.; Nikishin, I.A.; Gubina, E.D.; Pribylov, D.A.; Senchenkov, V.Y.; Sirotin, A.A.; Solyanikova, I.P. Assessment of the antifungal activity of the violacein-forming strain Janthinobacterium sp. B-3515 against the mold fungus Alternaria brassicicola F-1864. In Proceedings of the IOP Conference Series: Earth and Environmental Science, Volume 908. IV All-Russian Conference with International Participation “Diversity of Soils and Biota of Northern and Central Asia”, Ulan-Ude, Russia, 15–18 June 2021. [Google Scholar] [CrossRef]
- Netrusov, A.I.; Egorova, M.A.; Zakharchuk, L.M.; Kolotilova, N.N.; Kotova, I.B.; Semenova, E.V.; Tatarinova, N.Y.; Ugolkova, N.V.; Tsavkelova, E.A.; Bobkova, A.F. Practicum on Microbiology: Textbook for Students of Higher Educational Institutions, 1st ed.; Academia Publishing Center: Moscow, Russia, 2005; p. 608. [Google Scholar]
- Snegin, E.A. Practicum on Biometrics: Textbook; Publishing House “Belgorod” of the National Research University “Belgorod State University”: Belgorod, Russia, 2016; p. 56. [Google Scholar]
- Moiseichenko, V.F.; Trifonova, M.F.; Zaveryukha, A.K.; Eshchenko, V.E. Fundamentals of Scientific Research in Agronomy; Textbook for Students of Higher Educational Institutions: Moscow, Russia, 1996; p. 336. ISBN 5-10-003276-6. [Google Scholar]
- Netrusov, A.I.; Kotova, I.B. General Microbiology: Textbook for Students of Higher Educational Institutions, 3rd ed.; Publishing Center “Academy”: Moscow, Russia, 2007; p. 288. [Google Scholar]
- Akhapkina, S.; Seleznev, A.; Efimova, V.; Lyakhovchenko, N.; Solyanikova, I. Antagonistic activity of Pseudomonas chlororaphis against some mold fungi. BIO Web Conf. 2023, 66, 04006. [Google Scholar] [CrossRef]
- Avakova, A.; Lyakhovchenko, N.; Lopin, R.; Goltseva, E.; Belozerskikh, M.; Solyanikova, I. Antagonistic activity of the native strain of Pseudomonas chlororaphis 3 of the Belgorod region against the bacterium of the genus Ralstonia. BIO Web Conf. 2021, 40, 01008. [Google Scholar] [CrossRef]
- Bisswanger, H. Practical Enzymology; BINOM. Laboratory of Knowledge: Moscow, Russia, 2017; p. 328. [Google Scholar]
- State Standard (GOST), R. 54650-2011; Soils. Determination of Mobile Compounds of Phosphorus and Potassium Using the Kirsanov Method as Modified by TsINAO. Standartinform: Moscow, Russia, 2013.
- Hoshino, T.; Kondo, T.; Uchiyama, T.; Ogasawara, N. Biosynthesis of violacein: A Novel Rearrangement in Tryptophan Metabolism with a 1,2-Shift of the Indole Ring. Agric. Biol. Chem. 1987, 51, 965. [Google Scholar] [CrossRef]
- Huang, C.; Chu, X.; Hui, W.; Xie, C.; Xu, X. Study on extraction and characterization of new antibiotics violacein from engineered Escherichia coli VioABCDE-SD. Biotechnol. Appl. Biochem. 2023, 70, 1582–1596. [Google Scholar] [CrossRef] [PubMed]
- Gwon, D.; Seo, E.; Lee, J.W. Construction of Synthetic Microbial Consortium for violacein Production. Biotechnol. Bioproc. Eng. 2023, 28, 1005–1014. [Google Scholar] [CrossRef]
- Mendes, A.S.; de Carvalho, J.E.; Duarte, M.C.; Durán, N.; Bruns, R.E. Factorial design and response surface optimization of crude violacein for Chromobacterium violaceum production. Biotechnol. Lett. 2001, 23, 1963–1969. [Google Scholar] [CrossRef]
- Duran, M.; Ponezi, A.N.; Faljoni-Alario, A.; Teixeira, M.F.; Justo, G.Z.; Durán, N. Potential applications of violacein: A microbial pigment. Med. Chem. Res. 2012, 21, 1524–1532. [Google Scholar] [CrossRef]
- Durán, N.; Justo, G.Z.; Ferreira, C.V.; Melo, P.S.; Cordi, L.; Martins, D. Violacein: Properties and biological activities. Biotechnol. Appl. Biochem. 2007, 48, 127. [Google Scholar] [CrossRef]
- Wang, H.; Jiang, P.; Lu, Y.; Ruan, Z.; Jiang, R.; Xing, X.-H.; Lou, K.; Wei, D. Optimization of culture conditions for violacein production by a new strain of Duganella sp. B2. Biochem. Eng. J. 2009, 44, 119–124. [Google Scholar] [CrossRef]
- Lyakhovchenko, N.S.; Travkin, V.M.; Senchenkov, V.Y.; Solyanikova, I.P. Bacterial violacein: Properties, biosynthesis and prospects of application. Appl. Biochem. Microbiol. 2022, 58, 568–577. [Google Scholar] [CrossRef]
- Cazoto, L.; Martins, D.; Ribeiro, M.; Durán, N.; Nakazato, G. Antibacterial activity of violacein against Staphylococcus aureus isolated from Bovine Mastitis. J. Antibiot. 2011, 64, 395–397. [Google Scholar] [CrossRef] [PubMed]
- Martins, D.; Costa, F.T.M.; Brocchi, M.; Duran, N. Evaluation of the antibacterial activity of poly-(D,L-lactide-co-glycolide) nanoparticles containing violacein. J. Nanopart. Res. 2011, 13, 355–363. [Google Scholar] [CrossRef]
- Dodou, H.V.; Batista, A.H.M.; Medeiros, S.C.; Sales, G.W.P.; Rodrigues, M.L.; Pereira, P.I.O.; Nogueira, P.C.N.; Silveira, E.R.; Grangeiro, T.B.; Nogueira, N.A.P. Violacein antimicrobial activity on Staphylococcus epidermidis biofilm. Nat. Prod. Res. 2020, 34, 3414–3417. [Google Scholar] [CrossRef] [PubMed]
- Yamada, Y.; Patel, N.; Fukuda, H.; Nagata, T.; Mitarai, S.; Azam, F. Bacterial surface roughness regulates nanoparticle scavenging in seawater. Limnol. Oceanogr. 2023, 68, 780–789. [Google Scholar] [CrossRef]
- Zheng, S.; Bawazir, M.; Dhall, A.; Kim, H.E.; He, L.; Heo, J.; Hwang, G. Implication of surface properties, bacterial motility, and hydrodynamic conditions on bacterial surface sensing and their initial adhesion. Front. Bioeng. Biotechnol. 2021, 9, 643722. [Google Scholar] [CrossRef] [PubMed]
- Cai, J.; Du, B.; Kang, L.; Guo, J. Antimicrobial compounds from Athyrium sinense damage the cell membrane of Clavibacter michiganensis subsp. sepedonicus. J. Appl. Bot. Food Qual. 2020, 93, 76–83. [Google Scholar] [CrossRef]
- Blaker, L.D. Difference in the Inhibitory Effects of violacein on Various Yeast Isolate Strains From the Hudson Valley Region. Sr. Proj. Spring 2023, 233, 49. [Google Scholar]

| Options | Parameters | ||||
|---|---|---|---|---|---|
| CFU/mL | log(CFU/mL) ± Δ | Mean Square Deviation, σ | Relative Error of Measurement, ξ% | Calculated Student’s Criterion of Reliability, t | |
| 0 Hour of Incubation (Initial Values) | |||||
| Pure culture of J. lividum VKM B-3705D (1.1) | 1.1 × 107 | 7.03 ± 1.0 | 0.1 | 1.1 | t(1.1–1.3) = 8.24 (a); t(1.2–1.4) = 6.51 (a); t(1.3–1.4) = 4.54 (a); t(2.1–2.3) = 3.87; t(2.4–2.2) = 1.31; t(2.4–2.3) = 0.48; t(3.1–3.3) = 49.6 (c); t(3.2–3.4) = 5.41 (b); t(3.4–3.3) = 21.5 (b); t(4.1–4.3) = 5.2 (a); t(4.2–4.4) = 5.2 (a); t(4.4–4.3) = 38 (b); |
| Pure culture of C. michiganensis VKM Ac-1402(1.2) | 2.5 × 106 | 6.4 ± 1.1 | 0.1 | 1.4 | |
| J. lividum VKM B-3705D culture in the presence of C. michiganensis VKM Ac-1402(1.3) | 3.0 × 106 | 6.5 ± 1.9 | 0.2 | 2.3 | |
| Culture of C. michiganensis VKM Ac-1402 in the presence of J. lividum VKM B-3705D(1.4) | 3.5 × 107 | 7.5 ± 1.1 | 0.1 | 1.2 | |
| 6 h incubation | |||||
| Pure culture of J. lividum VKM B-3705D(2.1) | 2.85 × 107 | 7.4 ± 1.5 | 0.2 | 1.6 | |
| Pure culture of C. michiganensis VKM Ac-1402(2.2) | 1.05 × 107 | 7.0 ± 0.3 | 0.03 | 0.3 | |
| J. lividum VKM B-3705D culture in the presence of C. michiganensis VKM Ac-1402(2.3) | 7.5 × 106 | 6.9 ± 0.4 | 0.04 | 0.4 | |
| C. michiganensis VKM Ac-1402 culture in the presence of J. lividum VKM B-3705D(2.4) | 7.0 × 106 | 6.8 ± 1.6 | 0.2 | 1.9 | |
| 12 h incubation | |||||
| Pure culture of J. lividum VKM B-3705D (3.1) | 7.25 × 1010 | 10.8 ± 1.8 | 0.2 | 1.3 | |
| Pure culture of C. michiganensis VKM Ac-1402(3.2) | 2.1 × 1013 | 13.3 ± 2.0 | 0.2 | 1.2 | |
| J. lividum VKM B-3705D culture in the presence of C. michiganensis VKM Ac-1402(3.3) | 5.5 × 1011 | 11.7 ± 1.5 | 0.2 | 1.0 | |
| Culture of C. michiganensis VKM Ac-1402 in the presence of J. lividum VKM B-3705D(3.4) | 6.9 × 1012 | 12.8 ± 0.9 | 0.1 | 0.5 | |
| 24 h incubation | |||||
| Pure culture of J. lividum VKM B-3705D(4.1) | 7.84 × 1011 | 11.9 ± 0.4 | 0.05 | 0.3 | |
| Pure culture of C. michiganensis VKM Ac-1402(4.2) | 1.5 × 1010 | 10.2 ± 1.9 | 0.2 | 1.5 | |
| J. lividum VKM B-3705D culture in the presence of C. michiganensis VKM Ac-1402(4.3) | 3.8 × 1013 | 13.6 ± 0.4 | 0.04 | 0.2 | |
| Culture of C. michiganensis VKM Ac-1402 in the presence of J. lividum VKM B-3705D(4.4) | 2.5 × 1011 | 11.4 ± 1.1 | 0.1 | 0.8 | |
| Options | Parameters | |||
|---|---|---|---|---|
| Specific Grow Increase, R | Growth Rate Constant, μ, CFU/h | Division Rate Constant, ν | Generation Time, g h−1 | |
| Pure culture of J. lividum VKM B-3515 | 0.5 | 0.7 | 1.1 | 0.9 |
| Pure culture of C. michiganensis VKM Ac-1402 | 1.1 | 1.3 | 1.9 | 0.5 |
| J. lividum BKM B-3515 culture in the presence of C. michiganensis VKM Ac-1402 | 0.8 | 1.0 | 1.5 | 0.7 |
| C. michiganensis BKM Ac-1402 culture in the presence of J. lividum VKM B-3515 | 0.7 | 1.0 | 1.5 | 0.7 |
| Position | Signal |
|---|---|
| 2 | 8.03 singlet |
| 5 | 7.20 ppm, multiplet |
| 7 | 6.77 ppm doublet, J 8.7 Hz |
| 8 | 7.33 ppm doublet J 8.9 Hz |
| 13 | 7.53 singlet |
| 19 | 8.89 ppm doublet J 8.1 Hz |
| 20 | 6.94 ppm triplet J 9.0 Hz |
| 21 | 7.19 ppm multiplet |
| 22 | 6.82 ppm doublet J 8.6 Hz |
| Options | Parameters | ||||
|---|---|---|---|---|---|
| Arithmetic Mean at 24 h of Cultivation, M ± Δ, OD | Relative Error of Measurement, ξ, % | Specific Growth Rate, R | Degree of Suppression of Specific Growth, IR, % | Student’s Criterion of Reliability | |
| Control (without test solutions)(1.1) | 0.37 ± 0.08 | 1.77 | 8.73 | IR(1.1–1.2) = 2.97% IR(1.1–1.3) = 37.9% IR(1.1–1.4) = 11.1% IR(1.1–1.5) = 9.05% IR(1.1–1.6) = 5.49% IR(1.1–1.7) = 10.42% | t(1.1–1.2) = 1.10; t(1.1–1.3) = 14.70 (a); t(1.1–1.4) = 1.67; t(1.1–1.5) = 1.00; t(1.1–1.6) = 1.57; t(1.1–1.7) = 1.10; |
| DMSO undiluted(1.2) | 0.36 ± 0.04 | 0.81 | 8.47 | ||
| Undiluted fraction in DMSO(1.3) | 0.31 ± 0.08 | 2.12 | 5.42 | ||
| DMSO–water at a ratio of 4:0.5(1.4) | 0.35 ± 0.03 | 0.71 | 7.76 | ||
| Fraction in DMSO–water at a ratio of 4:0.5(1.5) | 0.36 ± 0.05 | 1.13 | 7.94 | ||
| DMSO–water at a ratio of 4:0.25(1.6) | 0.37 ± 0.06 | 1.29 | 8.25 | ||
| Fraction in DMSO–water at a ratio of 4:0.25(1.7) | 0.36 ± 0.04 | 0.81 | 7.82 | ||
| Options | Parameters | ||||
|---|---|---|---|---|---|
| Arithmetic Mean at 24 h of Cultivation, M ± Δ, OD | Relative Error of Measurement, ξ, % | Specific Growth Rate, R | Degree of Suppression of Specific Growth, IR, % | Student’s Criterion of Reliability | |
| Control (without test solutions)(2.1) | 0.37 ± 0.08 | 1.77 | 8.73 | IR(2.1–2.2) = 25.5%; IR(2.1–2.3) = 39.7%; IR(2.1–2.4) = 9.6%; IR(2.1–2.5) = 4.58%; IR(2.1–2.6) = 1.49%; IR(2.1–2.7) = 11.91%; | t(2.1–2.2) = 8.33 (a); t(2.1–2.3) = 18.28 (a); t(2.1–2.4) = 1.00; t(2.1–2.5) = 1.57; t(2.1–2.6) = 0.77; t(2.1–2.7) = 1.67; |
| DMSO undiluted(2.2) | 0.3 ± 0.03 | 0.83 | 6.5 | ||
| Undiluted fraction in DMSO(2.3) | 0.28 ± 0.03 | 0.9 | 5.5 | ||
| DMSO–water at a ratio of 4:0.5(2.4) | 0.36 ± 0.05 | 1.13 | 7.89 | ||
| Fraction in DMSO–water at a ratio of 4:0.5(2.5) | 0.35 ± 0.05 | 1.17 | 8.33 | ||
| DMSO–water at a ratio of 4:0.25(2.6) | 0.36 ± 0.14 | 3.00 | 8.6 | ||
| Fraction in DMSO–water at a ratio of 4:0.25(2.7) | 0.36 ± 0.04 | 0.88 | 7.91 | ||
| Options | Parameters | ||||
|---|---|---|---|---|---|
| Arithmetic Mean at 24 h of Cultivation, M ± Δ, OD | Relative Error of Measurement, ξ, % | Specific Growth Rate, R | Degree of Suppression of Specific Growth, IR, % | Student’s Criterion of Reliability | |
| Control (without test solutions)(3.1) | 0.37 ± 0.08 | 1.77 | 8.73 | IR(3.1–3.2) = 11.8% IR(3.1–3.3) = 57.7% IR(3.1–3.4) = 0.69% IR(3.1–3.5) = 1.49% IR(3.1–3.6) = 2.29% IR(3.1–3.7) = 2.99% | t(3.1–3.2) = 2.61 (a); t(3.1–3.3) = 14.70 (b); t(3.1–3.4) = 0.24; t(3.1–3.5) = 1.73; t(3.1–3.6) = 1.00; t(3.1–3.7) = 1.41 |
| DMSO undiluted(3.2) | 0.35 ± 0.03 | 0.71 | 7.71 | ||
| Undiluted fraction in DMSO(3.3) | 0.19 ± 0.03 | 1.33 | 3.69 | ||
| DMSO–water at a ratio of 4:0.5(3.4) | 0.36 ± 0.06 | 1.32 | 8.67 | ||
| Fraction in DMSO–water at a ratio of 4:0.5(3.5) | 0.36 ± 0.075 | 1.60 | 8.6 | ||
| DMSO–water at a ratio of 4:0.25(3.6) | 0.36 ± 0.062 | 1.34 | 8.53 | ||
| Fraction in DMSO–water at a ratio of 4:0.25(3.7) | 0.36 ± 0.08 | 1.82 | 8.47 | ||
| Options | Relative Error of Measurement, ξ, % | Enzyme Activity, IU/min | Degree of Suppression of Enzyme Activity, IR | Student’s Criterion of Reliability, t |
|---|---|---|---|---|
| Control variant without ATP-ases (Blank)(1) | 1.68 | - | IR(2–3) = 8.3%; IR(2–4) = 31.5% | t(1–2) = 44.8 (b); t(3–2) = 4.17 (a); t(4–2) = 11.39 (b); t(5–2) = 9.76 (b); t(6–2) = 2.1; t(7–2) = 1.4; t(8–2) = 0.87; t(4–3) = 16.65 (b) |
| Control variant containing ATP-ase(2) | 1.63 | 0.1 | ||
| DMSO undiluted(3) | 1.33 | 0.09 | ||
| Undiluted fraction in DMSO (4) | 1.27 | 0.07 | ||
| DMSO–water at a ratio of 4:0.5(5) | 1.88 | 0.13 | ||
| Fraction in DMSO–water at a ratio of 4:0.5(6) | 1.00 | 0.1 | ||
| DMSO–water at a ratio of 4:0.25(7) | 0.68 | 0.1 | ||
| Fraction in DMSO–water at a ratio of 4:0.25(8) | 0.83 | 0.1 |
Disclaimer/Publisher’s Note: The statements, opinions and data contained in all publications are solely those of the individual author(s) and contributor(s) and not of MDPI and/or the editor(s). MDPI and/or the editor(s) disclaim responsibility for any injury to people or property resulting from any ideas, methods, instructions or products referred to in the content. |
© 2024 by the authors. Licensee MDPI, Basel, Switzerland. This article is an open access article distributed under the terms and conditions of the Creative Commons Attribution (CC BY) license (https://creativecommons.org/licenses/by/4.0/).
Share and Cite
Lyakhovchenko, N.S.; Efimova, V.A.; Seliverstov, E.S.; Anis’kov, A.A.; Solyanikova, I.P. Bacteriostatic Activity of Janthinobacterium lividum and Purified Violacein Fraction against Clavibacter michiganensis. Processes 2024, 12, 1116. https://doi.org/10.3390/pr12061116
Lyakhovchenko NS, Efimova VA, Seliverstov ES, Anis’kov AA, Solyanikova IP. Bacteriostatic Activity of Janthinobacterium lividum and Purified Violacein Fraction against Clavibacter michiganensis. Processes. 2024; 12(6):1116. https://doi.org/10.3390/pr12061116
Chicago/Turabian StyleLyakhovchenko, Nikita S., Viktoria A. Efimova, Evgeniy S. Seliverstov, Alexander A. Anis’kov, and Inna P. Solyanikova. 2024. "Bacteriostatic Activity of Janthinobacterium lividum and Purified Violacein Fraction against Clavibacter michiganensis" Processes 12, no. 6: 1116. https://doi.org/10.3390/pr12061116
APA StyleLyakhovchenko, N. S., Efimova, V. A., Seliverstov, E. S., Anis’kov, A. A., & Solyanikova, I. P. (2024). Bacteriostatic Activity of Janthinobacterium lividum and Purified Violacein Fraction against Clavibacter michiganensis. Processes, 12(6), 1116. https://doi.org/10.3390/pr12061116

